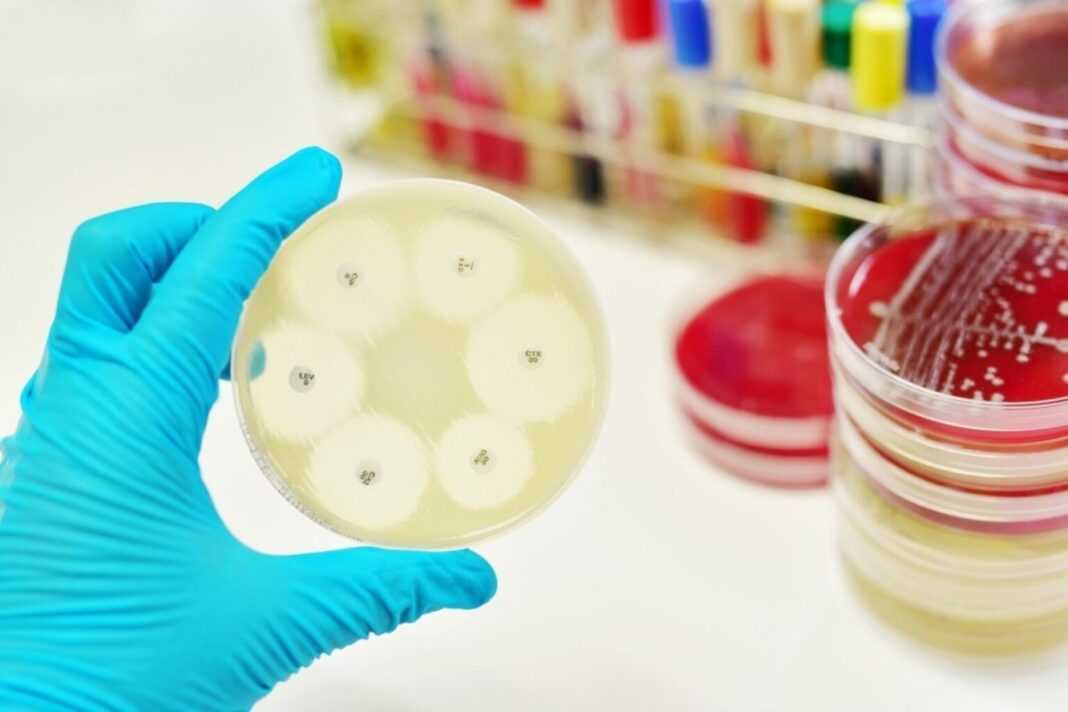

Ο Εθνικός Οργανισμός Δημόσιας Υγείας (ΕΟΔΥ) σε συνεργασία με την Εταιρεία Κλινικής Μικροβιολογίας και Εργαστηριακής Διαγνωστικής (ΕΚΜΕΔ), διοργανώνουν Διαδικτυακό Σεμινάριο την Παρασκευή 18 Μαρτίου 2022 (8.50-16.00) με σκοπό την επιμόρφωση και ενημέρωση του προσωπικού των Μικροβιολογικών Εργαστηρίων στο σύστημα ελέγχου της ευαισθησίας των βακτηρίων και μυκήτων στα αντιμικροβιακά (European Committee on Antimicrobial Susceptibility Testing, EUCAST).

Ο Οργανισμός European Centre for Disease Prevention and Control (ECDC) έχει συστήσει την εφαρμογή των οδηγιών της Ευρωπαϊκής Επιτροπής για τον Έλεγχο της Αντιμικροβιακής Ευαισθησίας (EUCAST) ως σύστημα ελέγχου για όλες τις χώρες στην Ευρώπη. Πλέον και στη χώρα μας εφαρμόζεται σε πολλά Μικροβιολογικά Εργαστήρια νοσοκομείων, κλινικών και μεγάλων διαγνωστικών κέντρων. Το σεμινάριο θα βιντεοσκοπηθεί και θα αναρτηθεί στην ιστοσελίδα της του ΕΟΔΥ και της ΕΚΜΕΔ ώστε να είναι δυνατή η παρακολούθησή του από όλα τα Εργαστήρια της χώρας. Για τη διευκόλυνση των Εργαστηρίων, θα αναρτηθούν στην ιστοσελίδα της ΕΚΜΕΔ καθώς και του ΕΟΔΥ, οδηγίες και πίνακες αναφορικά με την μετάβαση και εφαρμογή του συστήματος EUCAST μεταφρασμένες στα ελληνικά.
Μπορείτε να παρακολουθήσετε το σεμινάριο online χρησιμοποιώντας την πλατφόρμα: https://www.livemedia.com/eucast22.